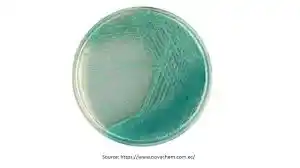

محیط کشت سودوموناس آگار
محیط کشت سودوموناس آگار کد 110989 یک محیط اختصاصی و انتخابی برای شناسایی، جداسازی و رشد گونههای مختلف Pseudomonas بهویژه Pseudomonas aeruginosa است.
این محیط بهگونهای طراحی شده که شرایط لازم برای رشد این باکتریهای گرم منفی هوازی را فراهم کرده و همزمان رشد بسیاری از باکتریهای مزاحم را مهار میکند.
سودوموناس آگار با داشتن ترکیبات تغذیهای متعادل، املاح معدنی، مواد انتخابی و رنگدانههای محرک، موجب بروز رنگهای فلورسنت یا رنگدانههای خاص مانند پیوسیانین میشود که در تشخیص این جنس باکتری اهمیت فراوان دارد.
این محیط بهطور گسترده در آزمایشگاههای تشخیص طبی، صنایع غذایی، آب و فاضلاب، آزمایشگاههای تحقیقاتی میکروبی و مطالعات بیماریهای عفونی استفاده میشود. سودوموناسها میتوانند در شرایط سخت زنده بمانند؛ به همین دلیل شناسایی درست و سریع آنها برای کنترل آلودگی اهمیت دارد.
سودوموناس آگار با مهار رشد فلور نقشساز محیطی و تقویت رشد انتخابی، امکان جداسازی دقیق این باکتریها را فراهم میکند. کاربرد آسان، وضوح نتایج و توانایی ایجاد کلونیهای مشخص، آن را به یکی از ابزارهای مهم تشخیص سودوموناسها تبدیل کرده است.

در شرکت دانش پژوهان شیمی، اصالت و کیفیت کالا برای ما در اولویت است. شما میتوانید محیط کشت سودوموناس آگار را می توانید از برند معتبر Merck / Sigma را همراه با برگه آنالیز (COA)، بستهبندی استاندارد و مشاوره علمی تخصصی دریافت کنید.
📌 این محصول با کد 110989 آماده عرضه میباشد.
برای ثبت سفارش و دریافت قیمت روز، با کارشناسان ما تماس بگیرید:
-
☎️ تلفن: 02166859220(ساعات پاسخگویی: 8:30 تا 18:00)
-
📱 واتساپ: 09129618292 (پشتیبانی 24 ساعته)
دانشجویان، پژوهشگران و فعالان حوزه تحقیقاتی میتوانند با اطمینان خاطر، این ماده شیمیایی را از دانش پژوهان شیمی تهیه کنند و پروژههای آزمایشگاهی خود را با کیفیت و دقت بیشتری پیش ببرند.
محیط کشت سودوموناس آگار
محیط کشت سودوموناس آگار یکی از مهمترین محیطهای تخصصی در علوم میکروبشناسی است. این محیط شامل ترکیباتی است که نهتنها توانایی رشد سودوموناسها را افزایش میدهد، بلکه با انتخابگری مناسب، امکان کاهش رشد باکتریهای رقابتی را فراهم میکند.
سودوموناسها از باکتریهای فرصتطلب و مقاوم هستند و در بسیاری از محیطها از جمله تجهیزات پزشکی، محیطزیست، آب آشامیدنی، مواد غذایی و حتی بدن انسان یافت میشوند. شناسایی درست آنها برای تشخیص بیماریها، بررسی آلودگیهای محیطی و کنترل کیفیت مواد غذایی بسیار حیاتی است.
وجود موادی مانند منیزیم، پتاسیم، پپتونها، گلیسرول و ترکیباتی که تولید رنگدانههای فلورسنت را تحریک میکنند، باعث تمایز بهتر کلونیها میشود. این محیط غالباً به عنوان ابزار کلیدی در آزمایشگاههای بالینی برای شناسایی آفریدن کلونیهای سبز-آبی یا زرد فلورسنت استفاده میشود که نشانگر وجود سودوموناس آئروژینوزا است.
در این مقاله، ساختار، ویژگیها، خواص فیزیکوشیمیایی، کاربردها، مزایا، محدودیتها، خطرات و سوالات متداول درباره این محیط کشت بهصورت کامل و قابل درک توضیح داده میشود تا مرجعی مناسب برای دانشجویان، پژوهشگران و متخصصان آزمایشگاهی باشد.
- کد: 110989
- نام انگلیسی: Pseudomonas agar F (base)
- for microbiology
- اسم دوم: Pseudomonas agar F
- UNSPSC Code: 41106213
- NACRES: NA.74
- بسته بندی: 500 گرمی
شرکت دانش پژوهان شیمی واردکننده اصلی مواد شیمیایی آزمایشگاهی بخصوص برند مرک آلمان و سیگماآلدریچ در ایران می باشد. جهت خرید محیط کشت می توانید با همکاران این مجموعه تماس حاصل نمائید.
محیط کشت سودوموناس آگار کد 110989 یکی از محصولات تولیدی شرکت مرک merck می باشد. این شرکت یکی از بزرگترین کمپانی های تولیدی مواد شیمیایی آزمایشگاهی در جهان می باشد که در بین محققین و دانشمندان و… از جایگاه ویژه ای برخوردار است.
ساختار و ترکیبات محیط کشت سودوموناس آگار
📌 ترکیبات اصلی محیط:
- پپتونها و منابع نیتروژن
- منیزیم و پتاسیم
- گلیسرول (بهعنوان منبع انرژی)
- نمکهای ضروری
- ترکیبات محرک تولید پیوسیانین و فلوئورسئین
- آگار برای ایجاد بافت جامد
📌 عملکرد ترکیبات:
- پپتونها: رشد باکتری و سنتز پروتئین
- منیزیم و پتاسیم: تحریک تولید رنگدانههای اختصاصی
- گلیسرول: افزایش رشد Pseudomonas aeruginosa
- نمکها: ایجاد محیط مناسب برای رشد انتخابی
- آگار: فرمدهی کلونیها

خواص فیزیکوشیمیایی محیط کشت سودوموناس آگار
🌡 دمای مناسب رشد: 35–37°C
🎨 رنگ محیط: سبز مایل به زرد (قبل از کشت)
💧 حالت: جامد
⚗️ pH معمولی: حدود 7.0 ± 0.2
🔍 ویژگی بارز: تقویت تولید رنگدانههای سودوموناس
این ویژگیها کمک میکنند تا کلونیها ویژگیهای ظاهری مشخصی پیدا کنند و تشخیص باکتری تسهیل شود.
ویژگیهای محیط کشت سودوموناس آگار
⭐ 1. انتخابگری بالا
رشد بسیاری از باکتریهای غیرهدف را مهار میکند.
⭐ 2. تفکیکپذیری مناسب
کلونیهای سودوموناس ظاهر فلورسنت یا رنگ خاص تولید میکنند.
⭐ 3. غنی از مواد مغذی
ترکیبات آن انرژی موردنیاز باکتری را تأمین میکنند.
⭐ 4. قابلیت تشخیص سریع
ظاهر کلونیها در مدت کوتاهی قابل مشاهده است.
⭐ 5. مناسب برای research و diagnostic
در تحقیقات و آزمایشگاههای بالینی کاربردهای گسترده دارد.
دعوت ویژه برای بازدید از محصولات و مقالات ما
از شما دعوت میکنیم برای آشنایی بیشتر با محصولات آزمایشگاهی و مقالات تخصصی ما، سری به وبسایت بزنید و سایر محصولات از جمله کامفن کد 442505 را مشاهده کنید. هدف ما این است که فرآیند خرید شما سریعتر، آسانتر و با اطمینان کامل انجام شود.
همین حالا روی لینک زیر کلیک کنید و از محتوای آموزشی و محصولات متنوع ما دیدن کنید:
کاربرد اصلی محیط کشت سودوموناس آگار
۱. جداسازی اختصاصی سودوموناسها
این محیط یکی از بهترین گزینهها برای جداسازی انتخابی گونههای سودوموناس از نمونههای محیطی، غذایی و بالینی است و رشد باکتریهای مزاحم را محدود میکند.
۲. شناسایی سودوموناس آئروژینوزا
پراهمیتترین کاربرد آن، شناسایی سودوموناس آئروژینوزا از طریق تولید رنگدانههای فلورسنت و پیگمانتهای اختصاصی مانند پیوسیانین است.
۳. بررسی تولید پیگمان
این محیط با فرمولاسیون خاص خود امکان تحلیل دقیق تولید پیگمانهای فلورسنت و غیر فلورسنت در گونههای مختلف سودوموناس را فراهم میکند.
۴. پایش کیفیت آب
در آزمایشگاههای محیط زیست برای اندازهگیری آلودگی آبها و شناسایی حضور سودوموناس بهویژه در آبهای صنعتی و استخرها استفاده میشود.
۵. کنترل کیفیت صنایع غذایی
برای بررسی فساد مواد غذایی خصوصاً لبنیات، گوشت و سبزیجات که مستعد آلودگی به سودوموناس هستند، کاربرد گستردهای دارد.
۶. آزمایشهای تحقیقاتی باکتریولوژی
در تحقیقات دانشگاهی و پژوهشی جهت بررسی رشد، مقاومت، رفتار زیستی و الگوی پیگمانسازی باکتریهای سودوموناس مورد استفاده قرار میگیرد.
۷. بررسی فعالیت ضد میکروبی مواد
برای آزمون حساسیت باکتریها به مواد ضدعفونیکننده و آنتیمیکروبیال و مقایسه اثر بازدارندگی آنها بر رشد سودوموناس مناسب است.
۸. شمارش باکتریها در نمونههای پیچیده
در صنایع و آزمایشگاهها از آن برای شمارش انتخابی سودوموناسها در نمونههای حاوی میکروارگانیسمهای مختلف با دقت بالا استفاده میشود.

شرایط خرید محیط کشت سودوموناس آگار از دانشپژوهان شیمی
برای خرید محیط کشت سودوموناس آگار کد 110989 از سایت رسمی دانشپژوهان شیمی، کافیست مراحل ساده زیر را دنبال کنید:
🔹 استاندارد بستهبندی و ایمنی:
این محصول باید در ظروف مقاوم، دربسته و عایق رطوبت بستهبندی شود تا خواص آن در حین حملونقل و نگهداری دچار تغییر نشود.
🔹 تأمین از برندهای معتبر:
ما این ماده را تنها از برندهای مطرحی مانند Merck (مرک) و Sigma-Aldrich (سیگما آلدریچ) تأمین میکنیم تا بالاترین خلوص و کیفیت برای شما تضمین شود.
🔹 مناسب برای مصرف آزمایشگاهی و صنعتی:
در صورت نیاز به خرید جزئی یا عمده، کارشناسان ما آماده ارائه مشاوره علمی و فنی پیش از خرید هستند.
📦 موجودی در بستهبندیهای متنوع
قابل ارائه در بسته بندی: 500 گرمی با ارسال سریع به سراسر کشور.
📞 ثبت سفارش و دریافت مشاوره تخصصی:
برای ثبت سفارش یا دریافت قیمت بهروز، با ما تماس بگیرید یا فرم سفارش را از طریق وبسایت تکمیل کنید.
تلفن: [02166859216 – 02166859220 – 09129618292]
ایمیل: [info@daneshpazhoohaneshimi.com]
سایت: [www.daneshpazhoohaneshimi.com]
🎯 همین حالا اقدام کنید!
محیط کشت سودوموناس آگار کد 110989 خالص و آزمایشگاهی را با شرایط ویژه از تأمینکننده معتبر دریافت نمایید.
خرید محیط کشت سودوموناس آگار
شرکت دانش پژوهان شیمی که نمایندگی مرک آلمان و نمایندگی سیگماآلدریچ در ایران، با همکاری کارشناسان مجرب خود در بخش فنی و فروش، جهت تامین مواد اولیه پژوهش های تحقیقاتی ماده های با کیفیت بالا و قیمت مناسب را فراهم نموده است. شما می توانید جهت خرید محیط کشت سودوموناس آگار با بخش فروش شرکت دانش پژوهان شیمی تماس حاصل بفرمایید و پس از دریافت پیش فاکتور و اطمینان حاصل نمودن از صحت نام محصول، کد، شماره CAS نامبر مواد شیمیایی درخواستی اقدام به ثبت سفارش نمایید تحویل کالاهای خریداری شده و زمان تحویل آنها به صورت زیر می باشد.
- زمان ارسال سفارشات از انبار: ۲۴ تا ۴۸ ساعت کاری می باشد
- نحوه ارسال کالای مشتریان: تهران توسط پیک
- ارسال شهرستان: توسط شرکت های حمل و نقل ( ترمینال، پست، تیپاکس)
مزایا و معایب محیط کشت سودوموناس آگار
💎 مزایا
- سرعت بالای شناسایی سودوموناس
- تفکیک رنگی بسیار واضح
- قابلیت کشت در شرایط ساده آزمایشگاهی
- قابل استفاده برای نمونههای بالینی، محیطی و غذایی
- انتخابگری مناسب در برابر باکتریهای مزاحم
⚠️ معایب
- برخی گونههای غیرسودوموناس ممکن است رشد خفیف داشته باشند
- برای تشخیص قطعی نیاز به تستهای تکمیلی است
- شرایط آمادهسازی باید دقیق باشد تا تولید رنگدانه مختل نشود
☣️ خطرات و نکات ایمنی محیط کشت سودوموناس آگار
⛔ خطر آلودگی با باکتریهای بیماریزا
⛔ احتمال انتقال عفونت در صورت بیاحتیاطی
⛔ نیازمند استفاده از هود میکروبی و تجهیزات حفاظتی
⛔ عدم لمس محیط کشت بدون دستکش
⛔ دورریز باید طبق اصول پسماند بیولوژیک انجام شود
❓ سوالات متداول محیط کشت سودوموناس آگار
🔸 این محیط برای چه باکتریهایی مناسب است؟
بهطور اصلی برای Pseudomonas aeruginosa و برخی گونههای سودوموناس.
🔸 آیا کلونیها رنگ خاصی ایجاد میکنند؟
بله، معمولاً سبز-آبی یا زرد فلورسنت.
🔸 آیا نیاز به افزودن مکمل دارد؟
در اغلب موارد خیر.
🔸 شرایط نگهداری چگونه است؟
در جای خشک، خنک و دور از تابش مستقیم نور.
🔸 آیا برای نمونههای بالینی مناسب است؟
بله، یکی از محیطهای اصلی در تشخیص عفونتهای سودوموناسی است.
قیمت فروش محیط کشت سودوموناس آگار
شرکت دانش پژوهان شیمی یکی از بزرگترین وارد کنندگان و فروشندگان مواد شیمیایی، آزمایشگاهی بخصوص فروش محیط کشت سودوموناس آگار که از محصولات نمایندگی مرک آلمان می باشد. این شرکت در زمینه واردات محصولات از تجربه بسیار بالایی برخوردار است. شما می توانید جهت تهیه این محصولات (اصلی) با بخش فروش شرکت تماس گرفته و با کارشناسان این شرکت در ارتباط باشید. از طریق کانال واتساپ شرکت نام محصول به همراه میزان نیاز خود را ارسال تا در کمترین زمان پاسخ استعلام خود را دریافت نمائید. امیدواریم بتوانیم با ارائه محصولات اصلی و با بهترین کیفیت شما را برای رسیدن به اهدافتان یاری نمائیم.
جهت محصولات بیشتر واستعلام سریع قیمت محیط کشت سودوموناس آگار میتوانید از طریق کانال واتساپ شرکت با ارسال نام ماده و مقدار نیاز در کمترین زمان پاسخ استعلام خود را دریافت نمائید.
راههای ارتباطی
شماره های تماس:
021-66859216
021-66859220 (ساعات تماس:8.30 الی 19)
واتساپ:09129618292 (24ساعت)
Last Updated on 12/14/2025 by adminm



